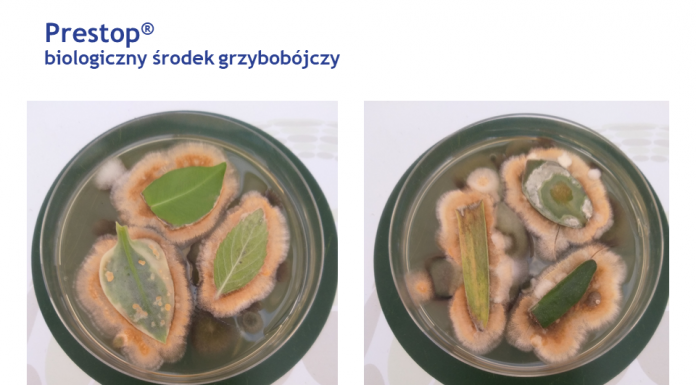
Nowe możliwości uprawy truskawek bez pozostałości

Przed nami kolejny sezon na plantacjach borówki i występujące jak zwykle zagrożenia ze strony chorób. Efektywny program ochrony borówki przed chorobami wymaga wykonania kilku...
W początkach kwietnia truskawki najwcześniejszych odmian testowane w projekcie Truskawki w tunelach, realizowanym przez firmę Haygrove oraz portal jagodnik.pl, już kwitną. Na niektórych roślinach...
Statystycznie rzecz ujmując, gospodarstwa w których uprawia się w Polsce truskawki są niewielkie. Małe możliwości stosowania płodozmianu, lub zupełny ich brak sprawiają, że ogrodnicy...
Ważnym czynnikiem definiującym plonowanie truskawek i ich jakość jest właściwe dostosowanie nawożenia i ochrony. Mówił o tym w ramach on-line Akademii Uprawy Truskawek 2020...
Firma Osadkowski SA od ponad 10 lat ściśle współpracuje z producentami owoców jagodowych. W ciągu tego czasu wdrożyła do praktyki wiele sprawdzonych m.in. w...
Jedną
z najbardziej znanych chorób spośród występujących na plantacjach truskawek
jest szara pleśń powodowana przez stadium konidialne grzyba Botrytis cinerea. Patogen może infekować wszystkie organy roślinne....
Tegoroczna edycja Akademii Uprawy Truskawek, która składała się z dwóch konferencji – we Wrocławiu i Czerwińsku nad Wisłą – z powodu pandemii koronawirusa została...
Jeszcze na początku tego roku, gdy spotykaliśmy na licznych wydarzeniach branżowych, nikt nie przewidywał, z jakimi problemami przyjdzie nam się zmierzyć w obliczu epidemii...
Najpopularniejszymi owocami w Polsce są jabłka, truskawki, czereśnie, śliwki, gruszki, maliny, wiśnie, borówki, porzeczki i aronia. Spośród wszystkich warzyw Polacy najczęściej jedzą pomidory, ogórki,...
Prezentowane rozwiązania mają na celu przeciwdziałanie skutkom COVID-19 - epidemii, z którą aktualnie walczy cały świat. To nie koniec podobnych rozwiązań. Trwają już prace...